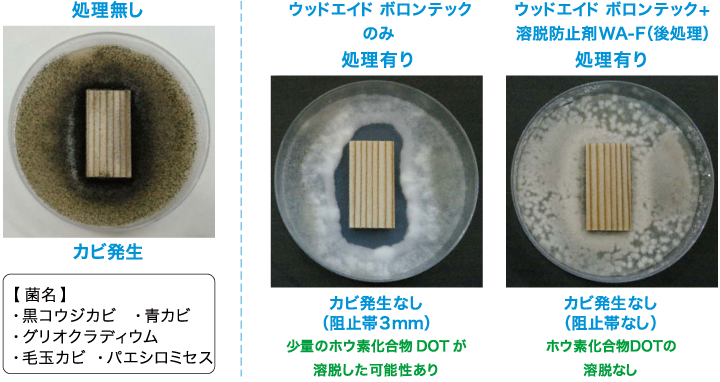
カビ抵抗性試験 pc

ウッドエイド ボロンテックは人と環境にやさしいホウ素化合物DOT(八ホウ酸二ナトリウム四水和物)にウッドエイドと安全性の高い防カビ剤及び濡れ剤WA-Pを組み合わせたもので、木材に撥水性と防虫、防腐、防カビ、防藻効果を付与し、劣化生物(腐朽菌、シロアリ、キクイムシなど)から守ります。また通気性にもすぐれるため、木材の呼吸を妨げません。また、溶脱防止剤WA-Fとの併用で、さらに溶脱防止効果を向上させることができます。
特長その1
長期間安全に木材を保存
これまでのホウ素化合物DOTは水溶性であるがゆえに屋外用途では雨水などで溶脱してしまい、また吸湿性の高さから木材の含水率が高くなるといった欠点がありました。その問題解決になったのがウッドエイドの配合です。ウッドエイドがつくる木材表面の呼吸する撥水性皮膜がホウ素化合物DOTの溶脱を抑え、防虫、防腐、防藻効果の持続性を向上させるとともに含水率を低く抑えます。
※常に雨水に曝される屋外での使用の場合はWA-Fとは併用をおすすめします。




八ホウ酸二ナトリウム四水和物の別称で、米国やトルコなどの鉱脈から採掘される天然素材です。合成殺虫剤に比べ、安全性が高く、分解や揮発することが無いため長時間効果の持続性が期待できる優れた素材です。欧米諸国では土台や柱など構造部材にはDOT処理が一般的に使用されており、日本では2008年に加圧注入用保存剤として承認され、2011年には表面処理用保存剤として認定されました。DOTの弱点は水溶性が高く、雨などに曝されると溶脱してしまうため外部での使用が困難でした。
特長その2
WA-Fでさらに溶脱を抑制
WA-FはDOTの溶脱防止剤です。WA-FがDOTの一部と反応して水に不溶な化合物を木材表面近くに薄く作ることにより、DOTの溶脱防止効果を付与します。
※WA-Fの単独使用だけではDOT溶脱防止効果の持続性が得られません。ご使用の際は必ずウッドエイド、
ウッドエイド ライト、ウッドエイド ボロンテックの何れかの製品と併用してください。
特長その3
防虫・防腐・防藻に加え防カビ効果も発揮
安全性の高い防カビ剤を配合しているので、美しさもより長持ちします。
カビ抵抗性試験
JIS Z 2911B法に基づくカビの抵抗性試験では、ウッドエイド ボロンテック処理は、カビの発育が認められなかったが肉眼及び顕微鏡下で平均3mmの阻止帯ができました。
ウッドエイド ボロンテックに溶脱防防止剤WA-Fを後処理をした場合は、カビの発育が認められない上に阻止帯の発生もないことから、溶脱が更に抑えられていることも確認されました。

●アメリカカンザイシロアリの予防処理にも効果的!
アメリカカンザイシロアリは外壁、庇、屋根裏、天井などから浸入してくるので、防除はもとより予防処理も困難でした。また床下に使うイエシロアリ用の農薬を天井などの上部に使う場合、空気より重い農薬が居住空間に飛散する問題があります。この点において、ウッドエイド ボロンテックに配合されたホウ素化合物DOTは分解せず溶脱も抑えられているので長期間効果が持続し、空気中に飛散せず、安全性を確保した上でカンザイシロアリに対して非常に高い予防効果を発揮します。
※シロアリなどへの防蟻性能を十分に発揮させるためには0.15kg/㎡以上塗装してください。

特長その4
表面的なので既存建物に対応
ウッドエイド ボロンテックは水性なので取り扱いが簡単で、しかも場所も選ばず安全に使用できます。また、非クロム銅ヒ素系加圧用防腐防蟻薬剤ACQやクロム銅ヒ素系加圧用防蟻薬剤CCAといった注入処理薬剤と違い、大掛かりな加圧注入設備の必要も無く、塗るだけで処理できるため既存建物にも容易に対応できます。常に雨水に曝される屋外での使用の場合はWA-Fとの併用をおすすめします。


















